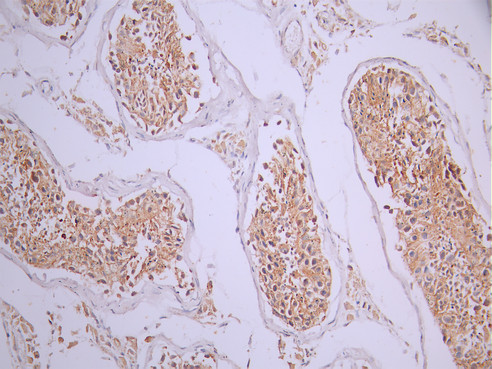

PVRL2 Recombinant Monoclonal Antibody
-
中文名稱:PVRL2 Recombinant Monoclonal Antibody
-
貨號:CSB-RA582013A0HU
-
規(guī)格:¥1320
-
圖片:
-
IHC image of CSB-RA582013A0HU diluted at 1:100 and staining in paraffin-embedded human testis tissue performed on a Leica BondTM system. After dewaxing and hydration, antigen retrieval was mediated by high pressure in a citrate buffer (pH 6.0). Section was blocked with 10% normal goat serum 30min at RT. Then primary antibody (1% BSA) was incubated at 4°C overnight. The primary is detected by a Goat anti-rabbit polymer IgG labeled by HRP and visualized using 0.05% DAB.
-
IHC image of CSB-RA582013A0HU diluted at 1:100 and staining in paraffin-embedded human prostate cancer performed on a Leica BondTM system. After dewaxing and hydration, antigen retrieval was mediated by high pressure in a citrate buffer (pH 6.0). Section was blocked with 10% normal goat serum 30min at RT. Then primary antibody (1% BSA) was incubated at 4°C overnight. The primary is detected by a Goat anti-rabbit polymer IgG labeled by HRP and visualized using 0.05% DAB.
-
-
其他:
產(chǎn)品詳情
-
Uniprot No.:
-
基因名:PVRL2
-
別名:CD 112 antibody; CD112 antibody; CD112 antigen antibody; Herpes virus entry mediator B antibody; Herpes virus entry protein B antibody; Herpesvirus entry mediator B antibody; Herpesvirus entry protein B antibody; Hve B antibody; HveB antibody; Nectin-2 antibody; Nectin2 antibody; Poliovirus receptor like 2 antibody; Poliovirus receptor related 2 (herpesvirus entry mediator B) antibody; Poliovirus receptor related 2 antibody; Poliovirus receptor related protein 2 antibody; Poliovirus receptor-related protein 2 antibody; PRR 2 antibody; PRR2 antibody; PVRL 2 antibody; PVRL2 antibody; PVRL2_HUMAN antibody; PVRR 2 antibody; PVRR2 antibody
-
反應(yīng)種屬:Human
-
免疫原:A synthesized peptide from human PVRL2 protein
-
免疫原種屬:Homo sapiens (Human)
-
標(biāo)記方式:Non-conjugated
-
克隆類型:Monoclonal
-
抗體亞型:Rabbit IgG
-
純化方式:Affinity-chromatography
-
克隆號:16F10
-
濃度:It differs from different batches. Please contact us to confirm it.
-
保存緩沖液:Rabbit IgG in 10mM phosphate buffered saline , pH 7.4, 150mM sodium chloride, 0.05% BSA, 0.02% sodium azide and 50% glycerol.
-
產(chǎn)品提供形式:Liquid
-
應(yīng)用范圍:ELISA, IHC
-
推薦稀釋比:
Application Recommended Dilution IHC 1:50-1:200 -
Protocols:
-
儲存條件:Upon receipt, store at -20°C or -80°C. Avoid repeated freeze.
-
貨期:Basically, we can dispatch the products out in 1-3 working days after receiving your orders. Delivery time maybe differs from different purchasing way or location, please kindly consult your local distributors for specific delivery time.
-
用途:For Research Use Only. Not for use in diagnostic or therapeutic procedures.
相關(guān)產(chǎn)品
靶點(diǎn)詳情
-
功能:Modulator of T-cell signaling. Can be either a costimulator of T-cell function, or a coinhibitor, depending on the receptor it binds to. Upon binding to CD226, stimulates T-cell proliferation and cytokine production, including that of IL2, IL5, IL10, IL13, and IFNG. Upon interaction with PVRIG, inhibits T-cell proliferation. These interactions are competitive. Probable cell adhesion protein.; (Microbial infection) Acts as a receptor for herpes simplex virus 1 (HHV-1) mutant Rid1, herpes simplex virus 1 (HHV-2) and pseudorabies virus (PRV).
-
基因功能參考文獻(xiàn):
- Nectin-2 mutation in men with severe teratospermia PMID: 28689229
- In the infection with 3 MLD50 (50 % mouse lethal dose), effective resistance was not observed in transgenic mice expressing nectin-2Ig. PMID: 28671524
- Our data provide important structural and biochemical determinants responsible for the recognition of nectin-2 by TIGIT. PMID: 27978489
- Chromosomal breakpoints involved the PVRR2 gene in 19q31 is associated with Diffuse Large B-Cell Lymphomas. PMID: 27356265
- energetic basis for the TIGIT/nectin-2 interaction and revealed that an "aromatic key" of nectin-2 is critical for this interaction, whereas variations in the lock were tolerated. PMID: 28515320
- PVRL2 is a plasma cholesterol-responsive gene acting at endothelial sites of vascular inflammation to regulate transendothelial migration of leukocytes. PMID: 28062492
- Serum levels of nectin-2 may have diagnostic roles for colorectal cancer patients. PMID: 26184725
- Soluble form of nectin-2 is required for exerting the resistance against HSV-2 infection. PMID: 26982466
- PVRL2, TOMM40 and APOE might be associated with human longevity. PMID: 24924924
- Nectin-3 trans-interacts with Nectin-2 to promote lymphocyte and monocyte extravasation. PMID: 24116228
- Chorionic gonadotropin induces vascular endothelial growth factor (VEGFA)-dependent downregulation of nectin 2, which increases the endothelial permeability in the coculture system. PMID: 23465821
- Structure of Nectin-2 reveals determinants of homophilic and heterophilic interactions that control cell-cell adhesion. PMID: 22927415
- a possible etiologic role of PRR2 in nonsyndromic cleft lip with or without cleft palate PMID: 20662561
- The CD112 is highly expressed in colon carcinoma tissues and cell lines. PMID: 20617580
- The authors now show that human cytomegalovirus targets CD112 for proteasome-mediated degradation by 48 h post-infection, thus removing both activating ligands for DNAM-1 from the cell surface during productive infection. PMID: 20410314
- differences in the N termini of herpes simplex virus type 1 and 2 gDs that influence functional interactions with the human entry receptor Nectin-2 PMID: 12915581
- There is an allelic association of sequence variation in PVRL2 and the severity of multiple sclerosis. PMID: 16738668
- CD226/CD112 (DNAM-1/Nectin-2) mast cell stimulation has a role in the allergic process PMID: 16831868
- identified PVRL2 as a new recurrent partner gene of the TRA@ locus in peripheral T-cell lymphoma PMID: 17696193
- Crystallization and preliminary X-ray analysis of the V domain of human nectin-2 are reported. PMID: 19478445
- Regions of nectin-2 protein important for herpesvirus entry activity and homotypic nectin-nectin interactions are overlapping but not identical. PMID: 12438620
顯示更多
收起更多
-
亞細(xì)胞定位:Cell membrane; Single-pass type I membrane protein.
-
蛋白家族:Nectin family
-
組織特異性:Ubiquitous.
-
數(shù)據(jù)庫鏈接:
Most popular with customers
-
-
YWHAB Recombinant Monoclonal Antibody
Applications: ELISA, WB, IHC, IF, FC
Species Reactivity: Human, Mouse, Rat
-
Phospho-YAP1 (S127) Recombinant Monoclonal Antibody
Applications: ELISA, WB, IHC
Species Reactivity: Human
-
-
-
-
-